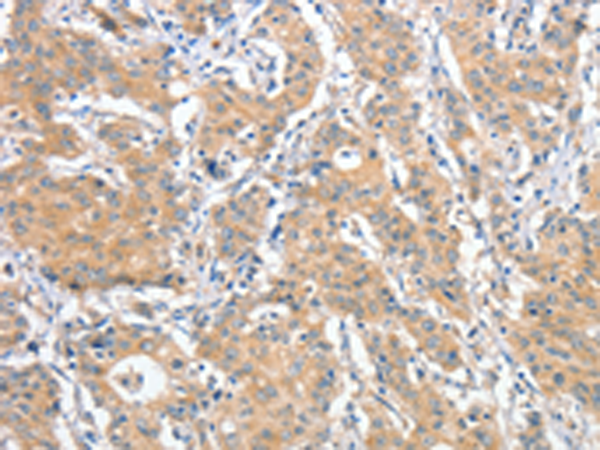

-
分类: 科研抗体货号: P07833别名: CALS-7; MDS015; ALS2CR1应用: WB,IHC反应种属: Human, Mouse, Rat
-
分类: 科研抗体货号: P07832别名: ALSJ; PLSJ; IAHSP; ALS2CR6应用: IHC反应种属: Human, Mouse, Rat
-
分类: 科研抗体货号: P07849别名: ZMYND20应用: IHC反应种属: Human, Mouse
-
分类: 科研抗体货号: P07831别名: LAK; 8430410J10Rik应用: IHC反应种属: Human
-
分类: 科研抗体货号: P07869别名: A3G; ARCD; ARP9; ARP-9; CEM15; CEM-15; MDS019; bK150C2.7; dJ494G10.1应用: WB,IHC反应种属: Human
-
分类: 科研抗体货号: P07848别名: ZMYND13应用: IHC反应种属: Human
-
分类: 科研抗体货号: P07830别名: ACTA; ASMA; CFTD; MPFD; NEM1; NEM2; NEM3; CFTD1; CFTDM应用: WB,IHC反应种属: Human, Mouse, Rat
-
分类: 科研抗体货号: P07868别名: C1orf169应用: IHC反应种属: Human
-
分类: 科研抗体货号: P07847别名: scra; Scraps应用: IHC反应种属: Human, Mouse
-
分类: 科研抗体货号: P07829别名: BDPLT15应用: WB,IHC反应种属: Human, Mouse, Rat

鄂公网安备42018502007531号
鄂公网安备42018502007531号

